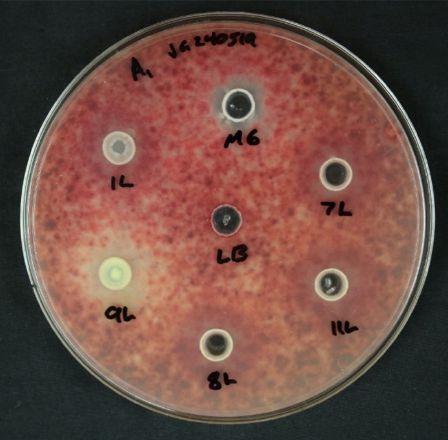

HARVEST MORE KNOWLEDGE
It’s time to renew your subscription to Top Crop Manager
Pleaseindicateyourjobtitle
TotalAcresPlanted/Represented
Demographics
FieldCropsPlanted(checkallthatapply,upto6)
CerealsForages/Pasture
PulseCropsOilseeds/Soybeans
PotatoesOther CornNotApplicable
Livestockinyouroperation(checkallthatapply,upto5)
BeefHogs SheepDairy
PoultryNotApplicable
NOT ONLY IS IT FREE, BUT IT’S ALSO EASY AND YOU HAVE OPTIONS:
Scan the QR code and submit the short form online.
Fill out the form to the left, and email a picture of it to: customercare@annexbusinessmedia.com
Call us at 1-416-510-5124 and mention you’re ready to renew. I promise, you’ll talk to a real human, from my team, and we won’t take much of your time.
I appreciate your timely attention to this.
Michelle Bertholet | Group Publisher, Agriculture www.topcropmanager.com/subscribe
KNOW. GROW.
Vol. 51, No. 2 topcropmanager.com
FERTILITY AND NUTRIENTS
6 BMPs for late-season nitrogen applications in corn
Assessing effects on yields, net returns and ammonia losses.
PESTS AND DISEASES
10Clubroot
a growing concern for Ontario canola growers
Removing disease from the field is not possible once established.
12Evolving a more potent fungus-killing machine
University of Guelph researchers developing bacteria that seek-and-destroy Fusarium and DON.
CROP BREEDING
14Eastern Canadian spring wheat – with a dash of Brazil
Drawing on South American germplasm for improved disease resistance and better climate resilience.
PESTS AND DISEASES
18 Managing tar spot
Your quick summary to identification, prevention, and treatment.
ON THE COVER: Clubroot arrives in Ontario’s Temiskaming District. Photo courtesy of Meghan Moran.
ON THE WEB
FARM
FINANCE
IS TOP OF MIND FOR PRODUCERS
In March, TopCropManager hosted a webinar about transition planning for the modern farm. The chat reviewed key considerations and pre-planning tools that can help set your farm for success and better business clarity. Catch up on this webinar and others you might have missed in the webinars section. topcropmanager.com
Readers will find numerous references to pesticide and fertility applications, methods, timing and rates in the pages of TopCropManager. We encourage growers to check product registration status and consult with provincial recommendations and product labels for complete instructions.


by Stephanie Gordon
The right kind of patience
Let’s be real — this growing season’s challenges go far beyond weather worries or input costs. Political shifts are shaking up markets, labour, exchange rates, and customer relationships. It’s enough to drive anyone crazy. What’s coming next? What can you do?
It’s easy to feel overwhelmed, but if anyone knows patience, it’s producers. You plant, nurture, and wait for the right harvest window. Yet, the virtue of patience often feels at odds with modern life. Phones buzzing, notifications demanding attention.
However, do not take what I’m saying as permission for procrastination, I’m simply saying that knowing what deserves your focus can help you stay grounded.
Take late-season nitrogen application in corn on page 6. Waiting to apply later in the season allows for fine-tuning based on in-season data. Why waste inputs when margins are tight? A small adjustment could boost yields and minimize environmental losses – if you’re willing to wait.
But waiting isn’t always wise. Clubroot is creeping into Northern Ontario’s canola fields (page 10), and early detection is critical. Early scouting and good management - like cleaning equipment, using resistant varieties, and longer crop rotations - can protect your fields.
The virtue of patience often feels at odds with modern life.
Then there’s the long game. On page 14, researchers in Eastern Canada are breeding more disease and heat-resistant hard red spring wheat. Crop breeding requires a steady approach as you mark, select, and breed new genetics into crop varieties. And then spend a couple more years registering them for use. Crop breeding isn’t fast, but rushing won’t yield better results. While it would be nice to have these varieties already, the goal is strong, resilient varieties, and that takes time.
The slow and steady approach is also what’s being advocated for biologicals. On page 12, a team of researchers at the University of Guelph are slowly developing bacteria that seeks and destroys Fusarium and DON. While some companies rush ineffective products to market, others take the slow, steady path to maximize efficacy of biologicals. It’s another battle between short-term gains and long-term success.
As you flip through these pages, I hope you reflect on the decisions you get to make during the growing season. What demands your immediate action and what can benefit from time? When the phone is ringing and notifications are pinging and distractions are piling up, check in with yourself. Am I making progress or just reacting out of habit?
Time is a funny thing. Sometimes we don’t have enough of it; other times, waiting is exactly what we need. As the season unfolds, I hope these pages help you decide when to act and when to be patient.

GORDON industry voice
topcropmanager.com

Take charge of your spraying accuracy through independent control of rate and pressure with SymphonyNozzle™ and a Gen 3 20|20® monitor. Together they reduce over-application with swath control and level out inconsistent application on turns. Take your sprayer a step further and add ReClaim™, our recirculation system.
WE BELIEVE IN BETTER SPRAYERS WITH BETTER CONTROL.



















BMPs for late-season nitrogen applications in corn
Assessing effects on yields, net returns and ammonia losses.
BY CAROLYN KING
If you are applying late-season nitrogen to your corn crop, what are the best management practices for maximizing corn yields and nitrogen-use efficiency while minimizing nitrogen losses to the environment?
This is the question that University of Guelph assistant professor Joshua Nasielski and his PhD student Jongwon Kang set out to answer through a major threeyear project, with the help of a big team effort to collect all the data.
By “late-season,” they mean applications after corn’s V8 growth stage and canopy closure. With the increasing availability of the high-clearance equipment used for such applications, more growers are considering splitting their crop’s nitrogen (N) fertilizer requirement between a planting time application and a late-season application.
Nasielski notes that the main advantage of a late-season application is the potential to use in-season data – soil data, weather data, crop data, market data – to fine-tune your nitrogen rates.
“The research suggests that you need to wait until after the typical sidedress timing around V6 to get
enough data to make a decision about whether or not this is a year where you should apply extra N to your crop. For example, some farmers will apply a moderate amount of nitrogen upfront around planting time that is good enough for their corn in most years. Then, if it turns out to be a really high-yielding year or if they had some early-season N losses, they do a late N application,” Nasielski explains.
Nitrogen fertilizer applied around planting has a longer time to be at risk of losses to the air and water than N applied in season. As well, a corn crop’s maximum N uptake occurs between about V9 and just before tasseling. So, applying some N in the weeks before silking has the potential to result in better N-use efficiency. Nasielski also says custom applicators generally like the flexibility of late-season timing and the opportunity to do an urea application very quickly.
However, late-season applications also have risks. “One of the main risks is yield reduction due to waiting too long before applying that late N so the crop suffers N stress,” Nasielski starts. “Another risk comes when you apply late N on the soil surface but then don’t receive enough rain to carry the fertilizer into the soil. So, the fertilizer is positionally unavailable to the corn roots when the crop needs it most . . . And when topdressing N after canopy closure, there is always a risk of leaf burn. It is somewhat of an open question as to whether this burn is cosmetic or results in a yield penalty.”
According to Nasielski, the proof-of-concept work for late-season N applications has already been done in corn growing areas in the United States and Canada. “Most of the research to date has shown that if you apply enough nitrogen upfront, you can delay a second application and still get a positive yield response, and you can get better nitrogen-use ef-
ficiency by applying in-season.”
However, corn growers have questions around late-season applications such as: how late is too late, how much N do you need upfront, and how big are the risks?
So, in this project, Nasielski and Kang wanted to determine what are the best N sources, N split and N placement options for late-season applications.
ABOUT THE PROJECT
The three-year project took place from 2021 to 2023 at the Ontario Crops Research Centre sites in Ridgetown, Winchester and Elora, and at two U.S. sites, one in Illinois and the other in Indiana.
The main collaborators with Nasielski and Kang were John Lauzon, David Hooker and Holly Byker, who are all with the University of Guelph, and Jason DeBruin with Corteva. Many other people also helped, including other scientists, post-doctoral researchers and graduate students.
The project team applied a total of 160 pounds of N per acre using three different splits, with some upfront and the rest at V10 to V13 (see Table 1). Nasielski points out, “We wouldn’t recommend applying as late as V13, especially in Ontario, because it is very close to silking, and you definitely want that N available at silking. We used that V13 timing to stress the system.” This timing shows what could happen if a grower’s planned late-application happens to get delayed until V10 or later.
For each split treatment, they compared four N sources: urea, UAN, urea with an urease inhibitor (UI, Agrotain Dri-Maxx), and UAN with UI – and two placements: surface-applied and injected (see Table 2).
TABLE 1. SPLIT APPLICATION TREATMENTS
PROPORTION OF N UPFRONT (STARTER + AT PLANTING)
Urease inhibitors reduce the activity of an enzyme that converts urea to ammonia; ammonia can be quickly lost to the air through volatilization. “Surface-applied N, especially in hot, humid weather, is very vulnerable to ammonia loss, so we focused on that,” Nasielski explains. “Although farm equipment to inject N after canopy closure is not available, we included injection treatments in the project for scientific reasons.” The team used specialized plot equipment to make the N injections and other late-season N applications.
The team collected comprehensive soil and weather data and measured ammonia volatilization, crop yields and other factors. The data analysis included assessment of the effects of the N treatments, soil properties and weather conditions on corn yields, return on investment, and ammonia losses.
Project funders included Grain Farmers of Ontario, Natural Sciences and Engineering Research Council of Canada, and the Ontario Agri-Food Innovation Alliance. Corteva provided in-kind support.
SPLIT TREATMENT FINDINGS
The V10 to V13 timing for the late-season N application turned out to be even riskier than expected.
As expected, the split N treatment with only 20 per cent upfront resulted in a yield reduction in almost all cases. “The split with only 30 pounds of N upfront and 130 pounds at V10 or later is definitely not a recommended practice. We did this treatment because we wanted to stress the system
So Much Power. So Little Effort.
Coragen® MaX insecticide provides fast, selective, extended control of western bean cutworm, corn earworm and more, in a convenient, concentrated formulation. It also works with beneficials** for a one-two punch that keeps the fight going long after you’ve left the field.
Controlling damaging insect pests doesn’t have to be a heavy lift.

TABLE 2. N SOURCE AND PLACEMENT TREATMENTS
Granular urea surface broadcast
Granular urea injected mid-row (2-inch depth)
Liquid UAN surface-applied as two bands about 7 inches from the corn row
Liquid UAN injected mid-row (2-inch depth)
Agrotain-treated granular urea surface broadcast
Agrotain-treated UAN surface-applied as two bands about 7 inches from the corn row
to see what would happen. The only places where we didn’t lose yield were in sandy and sandy loam soils,” Nasielski notes.
Although they expected some yield differences between the 50 and 70 per cent upfront treatments, they thought the yields of the two treatments would be quite similar. However, the differences were greater than expected. In 70 per cent of the cases, moving from 70 to 50 per cent upfront resulted in an average yield loss of 9 bushels per acre.
“Jongwon is investigating what was unique about the 30 per cent of site-years where we had a yield boost with 50 per cent upfront compared to 70 per cent upfront, as it is in those environments where late N yield gains are most likely,” Nasielski says.
So, for late-season N applications, make sure you apply enough N upfront. In many situations, 70 per cent upfront would be a safer bet than 50 per cent upfront.
SOURCE AND PLACEMENT FINDINGS
Overall, for reducing ammonia losses, injecting was the best placement choice followed by using an inhibitor with surface-applied N, and UAN was better than urea. “UAN injection, consistently across all the site years, led to the lowest ammonia losses,” Kang says.
“We also found that surface applying urea unprotected, with no inhibitor, resulted in much higher ammonia losses than surface applying UAN with no inhibitor. In fact, surface-applied UAN with no inhibitor resulted, on average, in similar amounts of losses from using urea with an inhibitor,” Nasielski says.
“We did expect that UAN would have lower volatilization losses than urea because UAN has half the amount of urea. With urea, 100 per cent of the nitrogen is in the urea form. With UAN, 50 percent of the nitrogen is urea, 25 per cent is in the ammonium form, and 25 per cent is in the nitrate form. But UAN had even lower losses than expected.”
Using an inhibitor always reduced volatilization losses for urea and for UAN. “However, the best bang for your buck was from using an inhibitor on urea just because losses with unprotected UAN were already
quite low,” Nasielski says.
However, Kang notes, “In many cases, we didn’t see a significant yield gain from using UAN injection compared to urea surface-placed or UAN surface-placed, even though we sometimes had more than a 90 per cent decrease in N losses with UAN injection. Only two site years had a significant yield response to N losses, and those were the site years that had really high economically optimal nitrogen rates, showing very strong N responsiveness.”
Nevertheless, the net returns for using an urease inhibitor were often positive. “For surface-applied urea at 50 pounds of N per acre, the net return from using an inhibitor was almost always positive, meaning the yield gain was greater than the additional cost of the UI. Positive return on investment was also much more likely than not for using a UI with surface-applied UAN. While a 3- to 4-bushel per acre yield bump from using a UI is not always statistically significant, it will more than pay for the cost of the inhibitor,” Nasielski points out.


Images like these of the different leaf burn percentages can help corn growers assess how much yield loss has occurred.
Top: Urea 65 with 10% damage
Above: UAN 132 with 90% damage
Cation exchange capacity (CEC) was the main soil factor influencing ammonia losses. Soils with a CEC above 23 milliequivalents (meq) per 100 grams had much lower losses. For these soils, the net returns from using an inhibitor tended to be relatively low because the ammonia losses were lower overall.
Rainfall was a key weather factor in ammonia losses. Overall, volatilization losses were: very low on dry soil until it rained; high after a rainfall event of less than about 1.2 inches; and low after a single rainfall event greater than about 1.2 inches that occurred soon after application.
Nasielski explains the general rule is if you have a rainfall event greater than 1 inch soon after a N application, then an inhibitor is not going to provide much benefit because the rainfall drives the urea into the soil so volatilization losses are low. However, later in the season, a rainfall event of 1.2 inches or more is needed to make a difference. That is because, with the denser canopy later in the season, less rain reaches the soil between the corn rows where the N was applied, and more rain flows down the corn stem to the base of the plant.
LEAF BURN STUDY
The project also included a study on leaf burn. Late-season topdress N that happens to get trapped in the corn plant’s whorl can cause leaf burn on the upper canopy leaves as they emerge. Also, dust from the urea that settles on the canopy can cause widespread leaf burn.
This study looked at leaf burn from topdress applications to understand how the degree of leaf burn re-
Table courtesy of Jongwon Kang and Joshua Nasielski, University of Guelph.
Photo courtesy of Gavin Brady, University of Guelph.
lates to crop yield.
Gavin Brady, one of Nasielski’s Master’s students, carried out this study, which involved applying urea or UAN at V10. Other research already shows inhibitors do not prevent leaf burn, so inhibitors were not used.
The N fertilizer was applied directly into the whorl to simulate topdress applications. The treatments included three N rates (130, 65 and 43 pounds per acre) for each N source, and a control with no N fertilizer in the whorl. At 12 days after the fertilizer application, Brady evaluated the V6 to V15 leaves, rating each leaf for the percentage of leaf area killed by the fertilizer.
The results showed that, once the average leaf burn area for the V9 to V15 leaves was greater than about 6 per cent, then the crop started losing yield. “Generally, if at least one leaf in the upper canopy is 50 per cent burned, that gets you to this 6 per cent threshold,” Nasielski notes.
Above that threshold, there was about a 0.5 to 1 per cent yield reduction for every 1 per cent increase in leaf damage.
Urea resulted in less burn damage than UAN. In fact, the damage from the urea treatments was often lower than the 6 per cent threshold. Higher N rates resulted in greater leaf damage.
The team has images of the different leaf damage percentages to help corn growers assess how much yield loss has occurred. These images provide a useful tool for growers in making decisions around whether they need to adjust their in-season N sources, rates, placement or timing to reduce or avoid leaf burn on the V9 to V15 leaves in the future.
KEY MESSAGES
“If you want to make an N adjustment later in-season, then I suggest applying upfront the amount you expect your crop to need in a lower yielding year,” Nasielski says.
Some of the situations with a lower risk of ammonia losses include: when UAN is used rather than urea; when an urease inhibitor is used; when N is applied to soils with a CEC higher than 23 meq per 100 grams; and when a single rainfall event of at least 1.2 inches is received soon after a late-season N application.
Using an urease inhibitor provides a bigger bang for your buck in situations with a higher risk of volatilization losses. “Surface applying urea with an inhibitor is a win-win environmentally and economically. UAN is a winner environmentally, and often a winner economically,” Nasielski says.
Once the average leaf burn area for the V9 to V15 leaves is greater than about 6 per cent, then the crop starts losing yield. That threshold is reached if one leaf in the upper canopy is 50 per cent burned. Beyond that threshold, the yield drops about 0.5 to 1 per cent for every 1 per cent increase in leaf damage.









UNCERTAIN ABOUT WHICH NOZZLES WORK BEST FOR PULSE WIDTH MODULATION CONTROL SYSTEMS?


Clubroot a growing concern for Ontario canola growers
Removing disease from the field is not possible once established.
BY MATT MCINTOSH
Clubroot is coming – and Ontario canola growers ought to take notice.
So says Meghan Moran, canola and edible bean specialist with the Ontario Ministry of Agriculture, Food and Agribusiness. While the pathogen has long been a part of canola production in Western Canada, it does not pick sides. Moran says the pathogen’s eastward expansion has begun causing significant yield losses on some farms in Ontario’s north and north-east arable areas. But while it might be impossible to remove clubroot once it’s established in the field, more vigilance and active management can significantly reduce production risks.
A “FUNGUS-LIKE” ORGANISM
The Canola Council of Canada describes clubroot as a “serious soil-borne disease” of cruciferous crops. It’s caused by a protist (single-celled organisms with plant, animal, and fungal qualities) that spreads through water, and manifests as swellings or galls on the roots of host plants. These galls damage root tissues, eventually killing the plant. If infection happens early or is severe enough in canola, the plant can die at or prior to pod fill.
The problem proved to be particularly bad for growers in Ontario’s Temiskaming District in 2024. Writing for Field Crop News in October of that year, Moran detailed how above-ground symptoms were notably worse than previous years in some areas, with some fields generating “essentially zero yield” because of premature death. “Thousands of acres” were affected

to some degree, she says, while the same story is likely to “play out across other Ontario spring and winter canola production areas where clubroot already exists, and as it continues to spread.”
HOW IT SPREADS
ABOVE In 2024, clubroot was bad in Ontario’s Temiskaming District with some fields generating “essentially zero yield” because of premature death.
Clubroot protists can only move short distances in soil moisture, and they require suitable host plants to thrive and proliferate. They can, however, move vast distances with soil via flowing water, and as hitchhikers on machinery. This is why the pathogen is often found at field entrances, or in fields vulnerable to flowing water. A telling example of clubroot’s mobility capability, Moran explains, is how it can colonize fields that never had susceptible host plants.
“When an old pasture field is ploughed down and planted to canola, how could there be clubs in that first season of production? The answer may lie in the ditches,” she says. “There are many fields in the Blanche River Valley with clubroot, for example. When there is excess water, it flows freely in ditches and across fields, potentially moving relatively long distances across the landscape. It pools in the corner of fields for days or weeks until conditions are drier. In this type of scenario, the soil is essentially shared and so too are the clubroot spores.”
Keith Gabert, Alberta-based agronomy specialist
Photo courtesy of Meghan Moran.
with Canola Council of Canada, says there’s usually a direct link between the appearance of clubroot in different fields. Speaking in December 2024, he says clubroot will “follow a water run through six or seven sections of land.” Frequent canola growers along that run can suddenly find themselves contending with very significant clubroot issues. Conversely, those who grow canola infrequently might be hard pressed to find the disease.
MITIGATING RISK
Speaking in February 2025, Moran says she has visually confirmed the presence of clubroot in spring canola as far south as Dufferin, Ont. She has yet to see it in winter canola, and believes the once-in-four-years rotations employed by winter canola growers in southern Ontario helps mitigate some risk. However, clubroot populations and its further spread could still be possible in areas where other host crops are grown – broccoli and cabbage, for example. Moran ranks clubroot very high on her list of concerning agronomic issues, calling it a “long-term” disease that can significantly hinder canola yields for years.
Planting clubroot-resistant canola varieties is one method of managing the disease. Mercedes – the only active registered winter canola variety in Ontario – is not resistant, but spring canola varieties are available with older tier-one resistance, as well as the more effective (and newer) two-tier resistance. The options within each are many, Moran says – although in Ontario, only two or three from each agriculture company are available to growers.

Cover crops like cereal rye can supress clubroot spores, and the same with a longer rotation with crops that do not act as a host. Moran recommends a minimum break of two years between canola and other brassica crops, such as camelina, but longer is better. Volunteer canola should be actively removed along with weeds that can host clubroot – those in the mustard family, for example. She adds planting “as early as possible” also helps ensure canola success because clubroot is less active in cool soils. Wet areas should also be particularly closely monitored. Biosecurity –that is, refraining from moving significant amounts of soil between fields via machinery and vehicles – is another possible means of preventing spread potential.
“The amount of spores present will build over time with every crop of canola,” Moran says, later reiterating the best scenario involves preventing clubroot from establishing itself in new fields in the first place.
“The key is long rotation, controlling volunteers, and just monitoring the crop closely. We need to be mindful this disease is here and will arrive on the farm. We need to scout diligently, and when it’s found, commit to managing it.”
Innovation unleashed.
Viatude™ fungicide with Onmira™ active delivers best-in-class defence against white mould. With multiple modes of action, you can count on premium protection that keeps your soybeans healthy all season long for higher yield potential.
Engineered excellence in every jug.
Evolving a more potent fungus-killing machine
University of Guelph researchers developing bacteria that seek-and-destroy Fusarium and DON.
BY MATT MCINTOSH
Interest and investment in biological crop protection and fertility products has increased dramatically in recent years, but consistent and measurable benefits from such products remain largely elusive.
For Manish Raizada, professor in the University of Guelph’s department of plant agriculture, part of the problem lies in evolution – or more specifically, a lack thereof in biological input development programs. Raizada’s experience suggests effective biological products can, however, be developed through targeted evolution.
BREED, EVOLVE, AND SELECT
The Crop Protection Network’s 2023 publication “Biopesticides for Crop Disease Management” argues more research is needed to “understand the efficacy of specific biopesticide products and their spectrum of disease control.” It also states research is required in a variety of other areas, including how biopesticides can be used effectively with synthetic pesticides – without sacrificing the efficacy of either product. Educational opportunities, too, are needed to help growers understand “the complicated terminology surrounding biological products and what factors can lead to their success (or failure) in a production system.”
Raizada reiterates many of the same points, but draws particular criticism to companies claiming their product will consistently work across a range of crops and conditions.
“That’s not what I see in the literature and it’s definitely not our experience,” Raizada says, referencing his own investigation into the validity of some efficacy claims. He later points to additional independent research from the United States indicating the yield benefits of nitrogen biological products remain elusive despite contrary claims from the manufacturer.
Raizada does, however, believe biological inputs have a bright future if companies “take the slow route” in the development of such products – that is, employ the “breed, evolve, and select” strategy widely used in the development of new crop varieties. Indeed, it is this method by which microbes that can seek-and-destroy fungal pathogens in corn and wheat are being developed.
EVOLVING DISEASE-DESTROYING BACTERIA
Raizada was involved in the “biological control and management of Fusarium head blight and associated diseases in organic grain production” – a
ABOVE In this petri dish test, 9L suppresses Fusarium growth, M6 is a positive control and LB is a negative control.
Canada-wide project under the 2018-2023 Organic Science Cluster. The aim was to investigate if microbiome changes in corn silks and wheat rachis – the main stem of the plant – after fungal infection was defensive in nature.
With this in mind, the researchers bio-prospected hundreds of microbes in corn silks and pollen identified as potential natural thwarters of Fusarium. These were cultured in petri dishes and tested for anti-Fusarium properties. Dozens showing positive results – and deemed safe to work with – were identified, and selected for further controlled indoor trials.
“Biologicals have a bright future if we take the slow route.”
“From those trials the pollen microbes were promising, but the silks were actually the best,” Raizada says. Some of the leading candidates could reduce DON mycotoxins and “a suite of Fusarium” toxins
Photo courtesy of Michelle Thompson, University of Guelph.
The Crop Protection Network’s 2023 publication “Biopesticides for Crop Disease Management” argues more research is needed to “understand the efficacy of specific biopesticide products and their spectrum of disease control.”
by as much as 90 per cent.
A similar process was followed for wheat. In both corn and wheat, some microbes brought very significant results in a lab setting. Effectiveness was notably lower in greenhouse trials, though, and further reduced in field conditions. Of the hundreds of microbes they started with, Raizada and his colleagues were left with just a few potentially effective organisms. This includes just one microbe for wheat, which proved effective at reducing DON levels to below one part-permillion when applied as a late-season spray in conjunction with fungicide. Year-to-year variability was also observed – something Raizada says is “typical” of biologicals. They are now evolving the most effective microbes to be better at seeking and destroying fungal pathogens.
“We realize now we don’t have something that’s good enough for growers. There are a couple years to go at this point,” says Raizada, adding Grain Farmers of Ontario and the National Science and Engineering Research Council of Canada have provided additional funding.
“No seed company would sell one seed variety and
expect it to work, but that’s what we’ve been doing with biologicals. We have to take the same approach that’s always been done in crop breeding or animal breeding.”
To-date, the researchers have successfully bred the most promising corn silk microbe into an organism that actively looks for and kills Fusarium. Like human immunity cells, Raizada says they are “literally moving towards the pathogen and chopping it up.” In summer 2025, this microbe will be tested in the field against the original started microbe strain. A similar process will eventually be followed in wheat.
Raizada believes their evolutionary approach will result in “a more potent killing machine” that could, one day, be a viable input available to growers. Many hurdles remain, including a lengthy regulatory process, and determining the best means of delivering the input – as a seed coating or spray, for example. He is excited with the success wrought by their approach thus far though, and hopes the ineffectiveness of biological products developed without evolution in mind does not spur a general backlash.
“I really think there’s a good future with biologicals,” Raizada says.
CFARMS_25-017_Ad_TopCropEast_Soy_East_7-125x4-75_v2.pdf 1 2025-03-03 10:17 AM

IMPORTANT
Bundle & tie tote bags. Place small bags (>25kg) into collection bag and seal securely. Empty & bag jugs; close bag securely.
Year a er year, Canadian farmers are keeping more ag plastics out of landfills.
Bring empty seed & pesticide bags to a Cleanfarms/AgriRÉCUP collection site for responsible waste management and your pesticide and fertilizer jugs, totes and drums for recycling.
COLLECTION SITES OPEN MAY 1*
info@cleanfarms.ca @cleanfarms
Quebec most sites are open all year long. Please check the map for details.
Eastern Canadian spring wheat – with a dash of Brazil
Drawing on South American germplasm for improved disease resistance and better climate resilience.
BY CAROLYN KING

Silvia Rosa brings a unique angle to her Quebec-based wheat research and breeding program. Through her links to the Brazilian wheat breeding community, she is tapping into some interesting genetics in South American cultivars. Her crosses are bringing fresh characteristics for hard red spring wheat varieties for Eastern Canada such as new resistance genes for diseases like Fusarium head blight (FHB) and greater tolerance to weather extremes.
ROSA’S BREEDING PROGRAM
Rosa joined the Centre de recherche sur les grains (CÉROM) in 2017 as the new head of its spring wheat breeding program. At that time, most of the program’s breeding material was derived from a former Agriculture and Agri-Food Canada (AAFC) breeding program in Quebec led by André Comeau. Since then, Rosa has been building on that foundation through crosses with germplasm from many sources for further trait improvement and to increase genetic diversity to strengthen resiliency to changing threats. Her breeding program mainly focuses on developing high-yielding, hard red spring wheat varieties with
ABOVE Rosa is working with this very diverse collection of wheat varieties from across South and North American to find possible parents for crosses to introduce broad adaptability and resiliency into Eastern Canadian hard red spring wheat.
superior milling and baking quality that meet the requirements of the Canada Eastern Red Spring (CERS) class. Lines that do not meet those quality requirements but have high yields and other good traits may be supported for registration as feed wheats.
Most of the CERS wheat grown in Quebec is for millers, bakers and wheat processors in Quebec. The provincial demand for Quebec-grown wheat is very strong, but meeting that demand can be difficult in part because Eastern Canada’s climate increases the risk of fungal diseases like FHB. Resistance to this destructive disease is a priority for Rosa’s program, along with quality and yield.
Other priorities include: resistance to preharvest sprouting; resistance to leaf rust and other rusts, leaf spots, and bacterial leaf streak; and tolerance of drought, high temperatures and flooding.
To advance breeding materials as quickly as possible, she and her team at CÉROM use a modified speed breeding protocol as well as molecular markers and CÉROM’s small quality lab to identify lines with good disease resistance and quality traits.
Photos courtesy of Silvia Rosa, CÉROM.
TOROPI: PART OF A FAMILY TRADITION
Rosa’s passion for wheat research comes naturally. “My parents used to work in EMBRAPA (the Brazilian Agricultural Research Corporation.) My father was a wheat breeder and my mom worked mainly as a plant pathologist in wheat. And my family has a breeding company in Brazil. So, I grew up always having them talking about wheat and having researchers at home talking about wheat.”
“I’m still helping the company there when possible. So, I have those contacts in Brazil and some knowledge about the characteristics of the cultivars,” she notes. “That helps me to bring some interesting Brazilian lines to be tested here and, if they have helpful characteristics, to make crosses here.”
Some of Rosa’s wheat research involves work with an old Brazilian variety called Toropi, which was released in Brazil in 1965. This cultivar has some remarkable disease resistance traits. For instance, its leaf rust resistance still remains effective against the disease 60 years later. Plus, it has multiple genes for resisting other diseases such as stripe rust, stem rust, FHB and powdery mildew.
Her mother’s PhD research at the University of




Minnesota investigated Toropi’s leaf rust resistance. “When I started my PhD at the University of Manitoba, in talking with my supervisors, we decided to continue that work. So, it is a family tradition, from generation to generation,” Rosa says.
Rosa’s PhD research included characterizing and mapping quantitative trait loci (QTL, locations on a genome associated with a specific trait) for resistance to leaf rust and stripe rust in Toropi and some work on Toropi’s stem rust resistance.
“When I started at CÉROM, I decided to continue working with the mapping population that we had developed for my PhD as that population was already genotyped. Since I knew that Toropi was also good for Fusarium head blight resistance, I wanted to know what was conferring that resistance,” she explains.
“We had trials in Morden, Man. with researchers from AAFC and here at CÉROM. In mapping the population for Fusarium head blight, we identified QTL that were located in the same regions as the QTL that we had mapped before for leaf rust, stripe rust and stem rust. That was very interesting to us because having co-localized genes or genes that have effects for more than one disease helps to introduce those multiple resistances into a new cultivar.”
They also discovered that the mapping population includes material with bacterial leaf streak resistance. So, Rosa and her team are collaborating with plant pathologist Dilantha Fernando at the University of Manitoba to screen for that.






“We have a new project that started in 2024, which is funded by Génome Québec, SeCan and Producteurs de grains du Québec. This project intends to fine-map Fusarium and rust resistance QTL, and resistance for other diseases like powdery mildew in that same population,” Rosa adds. She is very curious to see if the resistance genes for those other diseases are also in the same genomic regions as the FHB and rust resistance genes.
Work is underway to bring Toropi’s disease resistance traits into CÉROM’s wheat lines. “We have spring wheat populations from crosses that are already being selected in the field; we’re at four generations now. And this year, we are starting crosses to introduce the resistance into winter wheat,” Rosa says.
MORE BRAZILIAN RESISTANCE
When Rosa finished her PhD in 2013, she moved back to Brazil and worked in her family’s breeding company. However, in Brazil, it was difficult to genotype cultivars. So, she talked with Brent McCallum, a leaf rust pathologist from AAFC who was one of her PhD supervisors. They decided to launch a project to genotype and phenotype Brazilian cultivars under Canadian conditions. That way, Brazilian wheat breeders could benefit from the genotype data, and Canadian wheat breeders could identify possible lines for crosses to add further diversity to Canadian germplasm, especially for disease resistance.
“Brazilian cultivars are known to have good disease resistance because the disease pressure in Brazil is very strong,” Rosa notes. “The idea was to see if some of the material had sources of disease resistance that are different from the resistance used in Canadian wheat.”
The project’s initial disease focus was on leaf rust resistance, but as other researchers joined in, it expanded to include resistance to FHB, stripe rust, stem rust and powdery mildew.
The project team evaluated over 100 Brazilian wheat cultivars. In field and controlled environment experiments, they assessed the cultivars’ agronomic characteristics and response to Canadian pathogen strains, and they analyzed grain quality traits.
The researchers determined that many of the Brazilian cultivars were genetically distinct from Canadian wheat so they could be good sources for increasing genetic diversity in Canadian lines. As well, the results from the project’s agronomic trials at AAFC in Ottawa, Ont. and at CÉROM in Saint-Mathieu-de-Beloeil, Que. showed that several of the Brazilian varieties had yields as good as or better than the highest yielding Canadian checks.
The team also found resistance sources for diseases

like FHB and leaf rust that are different from the resistance used in Canadian germplasm. By using markers, they identified some of the resistance genes in the Brazilian cultivars, but more research is needed to better understand the resistance available in the Brazilian germplasm.
Rosa is already using some of these Brazilian cultivars in her breeding program to bring their disease resistance genes into her spring wheat lines.
SEEKING BROAD CLIMATE ADAPTATION
TOP Rosa and some of her plots at CÉROM to look for possible parents for crosses to introduce some great traits into Eastern Canadian hard red spring wheat.
Rosa is leading some international collaborative research to evaluate wheat cultivars from many countries for tolerance to weather extremes, a major threat to crop production in Canada and around the world.
“In the first project, we tested mostly for disease response and for adaptation in different field locations in Quebec. In the second project, we are screening more materials from Brazil, Paraguay, Uruguay, Chile, Argentina, Mexico, and Eastern and Western Canada,” she says.
The second project involves testing 150 cultivars in Quebec and in South America in some very different environments. In each environment, they are evaluating the cultivars’ agronomic traits, disease resistance, end-use quality and physiologic traits, such as root architecture and groundcover.
“We are looking for germplasms that can tolerate broad climatic conditions – lines that are good in drought, heat and flooding. So far, we have identified a few lines that are in the top list for yield in all or most of the environments. Broad adaptability and resilience
in maintaining high yield and high quality is what we are trying to introduce in the Eastern Canadian wheat material through crosses,” Rosa explains.
“Also, we are trying to identify if there are genomic regions related to broad adaptation and resilience to abiotic and biotic stress. If we can find some of those regions, then that would help with the introduction of those traits into the Canadian varieties.”
In another project, Rosa’s team is tackling the development of climate-resilient varieties from a different angle. This project aims to develop accurate high-throughput protocols to assess breeding material in the greenhouse and the field for response to drought, flooding and heat. The idea is that breeders won’t need to wait, for example, for a drought year to select for drought resistance.
Rosa’s team is experimenting with various ways to evaluate different growth stages of wheat plants for response to different weather stresses. For example, using hydroponically grown wheat seedlings, they are testing an osmotic system that mimics drought. Their work on possible field assessment methods includes experimenting with irrigation applications to simulate flooding and tents to create drought and high temper-
ature conditions.
Once the improved protocols are ready, Rosa’s team will be screening Quebec cultivars and advanced materials. They will also share the resulting information so wheat growers can choose the best cultivars for their own environment. This project is funded by MAPAQ (Quebec’s Agriculture Ministry) and Producteurs de semences du Québec, in collaboration with Réseau des Grandes Cultures du Québec, Synagri and Semican.
Although Rosa’s research and breeding work shows great promise for helping to deal with key challenges facing wheat production in Quebec and the rest of the East, that is not an easy task.
“The millers, bakers and wheat processors are searching for more wheat in Eastern Canada. They are very worried because the last two years were very difficult for wheat production [due to poor weather and serious problems with diseases like FHB]. The very low production was not enough for their needs. They want to at least double hard red wheat production in Eastern Canada,” she says.
“It is good that the industry is on our side, and we are doing what we can to find enough funding to continue our work.”
Brazilian cultivars are known to have good disease resistance because the disease pressure in Brazil is very strong.
Managing tar spot
Your quick summary to identification, prevention, and treatment.
BY STEPHANIE GORDON
Tar spot is an emerging fungal disease in Ontario cornfields, first detected in 2020. It presents as black, raised lesions that feel rough to the touch, like sandpaper. These lesions, called stroma, contain spores that can spread through wind and rain, leading to multiple infection cycles within a single growing season.Farmers should scout for tar spot in mid-to-late July, particularly in the lower canopy where dew lingers. Early detection is crucial, because the disease can lead to premature plant death, reduced grain yield, and compromised silage quality.
CONDITIONS FAVOURING TAR SPOT
The disease thrives in cool, humid conditions with prolonged leaf wetness, specifically:
• Temperatures between 17-25°C
• Humidity above 75 per cent
• Leaf wetness lasting at least seven hours
Frequent rain, fog, and heavy dew create an ideal environment for its spread. Areas in Ontario that have experienced white mould in soybeans should be particularly vigilant, as both diseases favour similar conditions. Additionally, resources like the Tar Spotter app and weather forecasts can aid in predicting disease risk and informing management decisions.
PREVENTION STRATEGIES
1. Hybrid selection: While there are no tar spot-resistant corn hybrids available in the Ontario market, all hybrids respond to a fungicide application during the silking stage.
2. Field scouting: Regular monitoring in July and August can help detect early infections and inform fungicide application decisions.
3. Crop rotation and tillage: While tar spot spores are airborne, crop rotation may help lower the initial spore load. Heavy tillage may reduce early infection, but it is not a guaranteed control method or enough to stop the disease. If you have good

reasons for your tillage methods, it is not advised to change them in response to this disease.
4. Nitrogen management: Maintaining adequate nitrogen levels can support plant health and reduce susceptibility.
TREATMENT
ABOVE Tar spot is present in southern Ontario, so early identification is more important than ever.
Fungicide application is the most effective control measure for tar spot. Research indicates that products with multiple modes of action (minimum of 2-3 groups) provide the best protection. The recommended application window is at the R1 (silking) stage, though early vegetative applications may be warranted if disease pressure is high. A fungicide application at the silking stage can also supress ear moulds and reduce DON levels in the grain. In high-risk conditions, a second fungicide pass may be beneficial, especially for early-planted or late-harvest fields.
KEY TAKEAWAYS
• Scout regularly in July and August for early signs of tar spot.
• Watch weather conditions (cool, humid environments increase risk.)
• Use a fungicide program with multiple modes of action at R1.
• Maintain nitrogen levels to keep plants healthy.
By staying proactive and informed, Ontario corn growers can minimize the impact of tar spot. For more on tar spot, visit topcropmanager.com/webinars.
Photo courtesy of Darcy Telenko.




Canadian agriculture and food needs more talented people.
Each year, CABEF helps students to pursue rewarding agri-food careers through seven $2,500 scholarships. We’re looking for the future leaders who will help this industry meet tomorrow’s challenges.
Do you know someone who needs to fund their future in agri-food? Tell a student today.
Scholarship application deadline is April 30, 2025
Want to help support the next generation of agri-food leaders?
Become a “Champion of CABEF.” This program allows your organization to directly sponsor a deserving student. Contact CABEF at info@cabef.org.